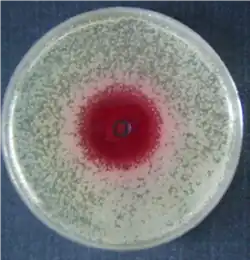

Roseoflavin
| Strukturformel | |||||||||||||
|---|---|---|---|---|---|---|---|---|---|---|---|---|---|
| |||||||||||||
| Allgemeines | |||||||||||||
| Name | Roseoflavin | ||||||||||||
| Andere Namen |
| ||||||||||||
| Summenformel | C18H23N5O6 | ||||||||||||
| Externe Identifikatoren/Datenbanken | |||||||||||||
| |||||||||||||
| Eigenschaften | |||||||||||||
| Molare Masse | 405,41 g·mol−1 | ||||||||||||
| Aggregatzustand |
fest | ||||||||||||
| Schmelzpunkt | |||||||||||||
| Löslichkeit | |||||||||||||
| Sicherheitshinweise | |||||||||||||
| |||||||||||||
| Wenn nicht anders vermerkt, gelten die angegebenen Daten bei Standardbedingungen (0 °C, 1000 hPa). | |||||||||||||
Roseoflavin („Roseo-“, engl., Präfix für rose-red) ist eine dem Wuchsstoff Vitamin B2 (Riboflavin) strukturell sehr ähnliche organische Verbindung, die aus dem Kulturfiltrat des grampositiven Bodenbakteriums Streptomyces davawensis isoliert werden kann. Dieses rosa bzw. rote Pigment zeigt gegenüber grampositiven Bakterien wie Bacillus subtilis oder Staphylococcus aureus antibiotische Wirkung. Roseoflavin ist das einzige bekannte, natürlich vorkommende Flavinanalogon mit antibiotischer Wirkung.
Vorkommen
Roseoflavin wird von dem Bodenbakterium Streptomyces davawensis synthetisiert. Streptomyces davawensis wurde im Rahmen eines „Screening“-Programms nach Antibiotika aus einer philippinischen Bodenprobe isoliert.[3] Weitere Untersuchungen durch ein japanisches Forscherteam ergaben, dass Streptomyces davawensis eine auffällige rosafarbene organische Verbindung produziert und in das Kulturmedium ausscheidet. Die Struktur des rosafarbenen Stoffes wurde mittels NMR-Spektroskopie aufgeklärt.[4]
Gewinnung und Darstellung

Roseoflavin kann aus dem Kulturüberstand von Streptomyces davawensis isoliert werden. Über die Biosynthese der Verbindung ist bisher nur wenig bekannt. Es wird allerdings davon ausgegangen, dass Roseoflavin über Riboflavin aus GTP gebildet wird. 2011 wurde das erste Enzym der Roseoflavin-Biosynthese identifiziert, eine SAM abhängige Methyltransferase, die die letzten beiden Reaktionen von 8-Amino-8-demethyl-D-Riboflavin nach Roseoflavin katalysiert. An die Aminogruppe am C8-Atom werden bei dieser Reaktion sukzessiv zwei Methylgruppen von zwei SAM-Molekülen übertragen.[5]
Durch verschiedene Extraktions- und Reinigungsschritte können aus dem Kulturfiltrat dunkelrote Kristalle gewonnen werden. Das Verfahren der Isolierung von Roseoflavin aus dem Kulturüberstand ist derzeit sehr aufwendig. Zusätzlich sind die Ausbeuten mit 0,5 mg/l Kulturüberstand sehr gering, so dass kommerziell erhältliches Roseoflavin mittels chemischer Synthese gewonnen wird.[6]
Eigenschaften
Roseoflavin bildet dunkelrote Kristalle und ist geruchlos. Roseoflavin ist sowohl in wässriger als auch organischer Lösung photosensitiv. Unter Einfluss von Sonnenlicht verfärbt es sich von rosa nach gelb. Schmelzpunkt: 276–278 °C. UV/VIS-Absorptionsspektrum: Wellenlänge (nm) (molarer Extinktionskoeffizient ·10−3) 223(14,0), 258(40,0), 314 (6,77), 505 (32,8) Roseoflavin ist sehr gut löslich in DMSO, löslich in Wasser (ca. 250 µM), Pyridin, Methanol, Aceton und n-Butanol. Roseoflavin ist nicht löslich in Benzol, n-Hexan, Chloroform und Tetrachlormethan.[1]
Biologische Bedeutung
Roseoflavin hat schwache antibiotische Wirkung gegen einige grampositive Bakterien wie Staphylococcus aureus, Sarcina lutea, Bacillus cereus und Bacillus subtilis (siehe auch Antivitamin). Diese antibiotische Wirkung ist darauf zurückzuführen, dass Roseoflavin als Riboflavin Antagonist wirkt. Roseoflavin bildet inaktive Kofaktoren für Flavoenzyme (FMN, FAD)[7] oder wirkt auf einen sogenannten Riboswitch ein.[8] Der genaue Mechanismus ist noch nicht bekannt. Roseoflavin hemmt außerdem die Reifung von Plasmodium falciparum, dem Erreger der Malaria beim Menschen.[9]
Weblinks
- Forschungsprojekt der Forschungsgruppe Matthias Mack (HS-Mannheim) – Roseoflavin-Biosynthese in Streptomyces davawensis (BMBF, ZAF, DFG) ( vom 8. Februar 2013 im Internet Archive)
Einzelnachweise
- ↑ a b c S. Otani et al.: Studies on roseoflavin: isolation, physical, chemical and biological properties. In: Flavins and flavoproteins. Band 33, 1976, S. 323–327.
- ↑ Dieser Stoff wurde in Bezug auf seine Gefährlichkeit entweder noch nicht eingestuft oder eine verlässliche und zitierfähige Quelle hierzu wurde noch nicht gefunden.
- ↑ S. Otani, M. Takatsu, M. Nakano, S. Kasai, R. Miura: Letter: Roseoflavin, a new antimicrobial pigment from Streptomyces. In: Journal of Antibiotics. Band 27, Nr. 1, 1974, S. 86–87, PMID 4843053.
- ↑ S. Otani, R. Miura, K. Matsui: Chemical Structure and Some Properties of Roseoflavin. In: Bulletin of the Chemical Society of Japan. Band 48, Nr. 10, 1975, S. 2877–2880, doi:10.1246/bcsj.48.2877.
- ↑ F. Jankowitsch, C. Kühm, R. Kellner, J. Kalinowski, S. Pelzer, P. Macheroux, M. Mack: A novel N,N-8-amino-8-demethyl-D-riboflavin Dimethyltransferase (RosA) catalyzing the two terminal steps of roseoflavin biosynthesis in Streptomyces davawensis. In: Journal of Biological Chemistry. Band 286, Nr. 44, 2011, S. 38275–38285, doi:10.1074/jbc.M111.292300, PMID 21911488, PMC 3207391 (freier Volltext).
- ↑ S. Otani, S. Kasai, K. Matsui: Isolation, chemical synthesis, and properties of roseoflavin. In: Methods in Enzymology. Band 66, 1980, S. 235–241, PMID 7374471.
- ↑ S. Grill, S. Busenbender, M. Pfeiffer, U. Köhler, M. Mack: The bifunctional flavokinase/flavin adenine dinucleotide synthetase from Streptomyces davawensis produces inactive flavin cofactors and is not involved in resistance to the antibiotic roseoflavin. In: Journal of Bacteriology. Band 190, Nr. 5, 2008, S. 1546–1553, doi:10.1128/JB.01586-07, PMID 18156273, PMC 2258686 (freier Volltext).
- ↑ K. F. Blount, R. R. Breaker: Riboswitches as antibacterial drug targets. In: Nature Biotechnology. Band 24, Nr. 12, 2006, S. 1558–1564, doi:10.1038/nbt1268, PMID 17160062.
- ↑ Matthias Mack: Mikrobiologie in Mannheim ( vom 22. September 2011 im Internet Archive). In: horizonte. Nr. 32, Juli 2008.
